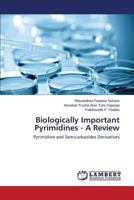
Biologically Important Pyrimidines - A Review 3659508241 Book Cover

- Ocena heterocykli pirazolowych w walce z rakiem - przegląd
- Évaluation des hétérocycles pyrazoliques contre le cancer - Une revue
- Bewertung von Pyrazol-Heterocyclen gegen Krebs - Eine Übersicht
- Avaliação dos heterociclos de pirazol contra o cancro - Uma revisão
- Valutazione degli eterocicli pirazolici contro il cancro - Una revisione